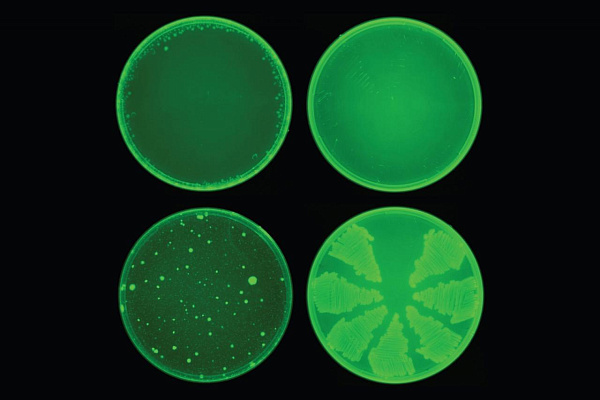

Использование искусственного интеллекта в медицине, похоже, начинает окупаться. Ученые Массачусетского технологического института обнаружили, что их ИИ обнаружил соединение антибиотиков, халицин, которое может не только убивать многие формы устойчивых бактерий, но и делать это новым способом – об этом
сообщает Engadget.
Там, где многие антибиотики слабо влияют на существующие лекарства, халицин демонстрирует в разы более мощный эффект. Он не просто уничтожает бактерии: антибиотик разрушает их способность поддерживать электрохимический градиент, необходимый для производства молекул, хранящих их энергию. Так, в испытании с кишечной палочкой, последняя не смогла развить никакой защиты от халицина за 30 дней, в то время как в случае с общепринятым антибиотиком ципофлоксацином ей потребовалось всего три дня, чтобы нарастить защиту.
Как объясняют учёные, их система на основе машинного обучения была настроена таким образом, чтобы всего за несколько дней провести анализ 100 миллионов химических веществ. Как результат, ИИ выявил оказавшийся невероятно эффективным антибиотик, в очередной раз подтвердив перспективность использования таких систем в фармакологии.
Халицин уже прошёл проверки на мышах и, вероятно, станет основой для более эффективных препаратов от устойчивых заболеваний.
Фото: Collins Lab / MIT